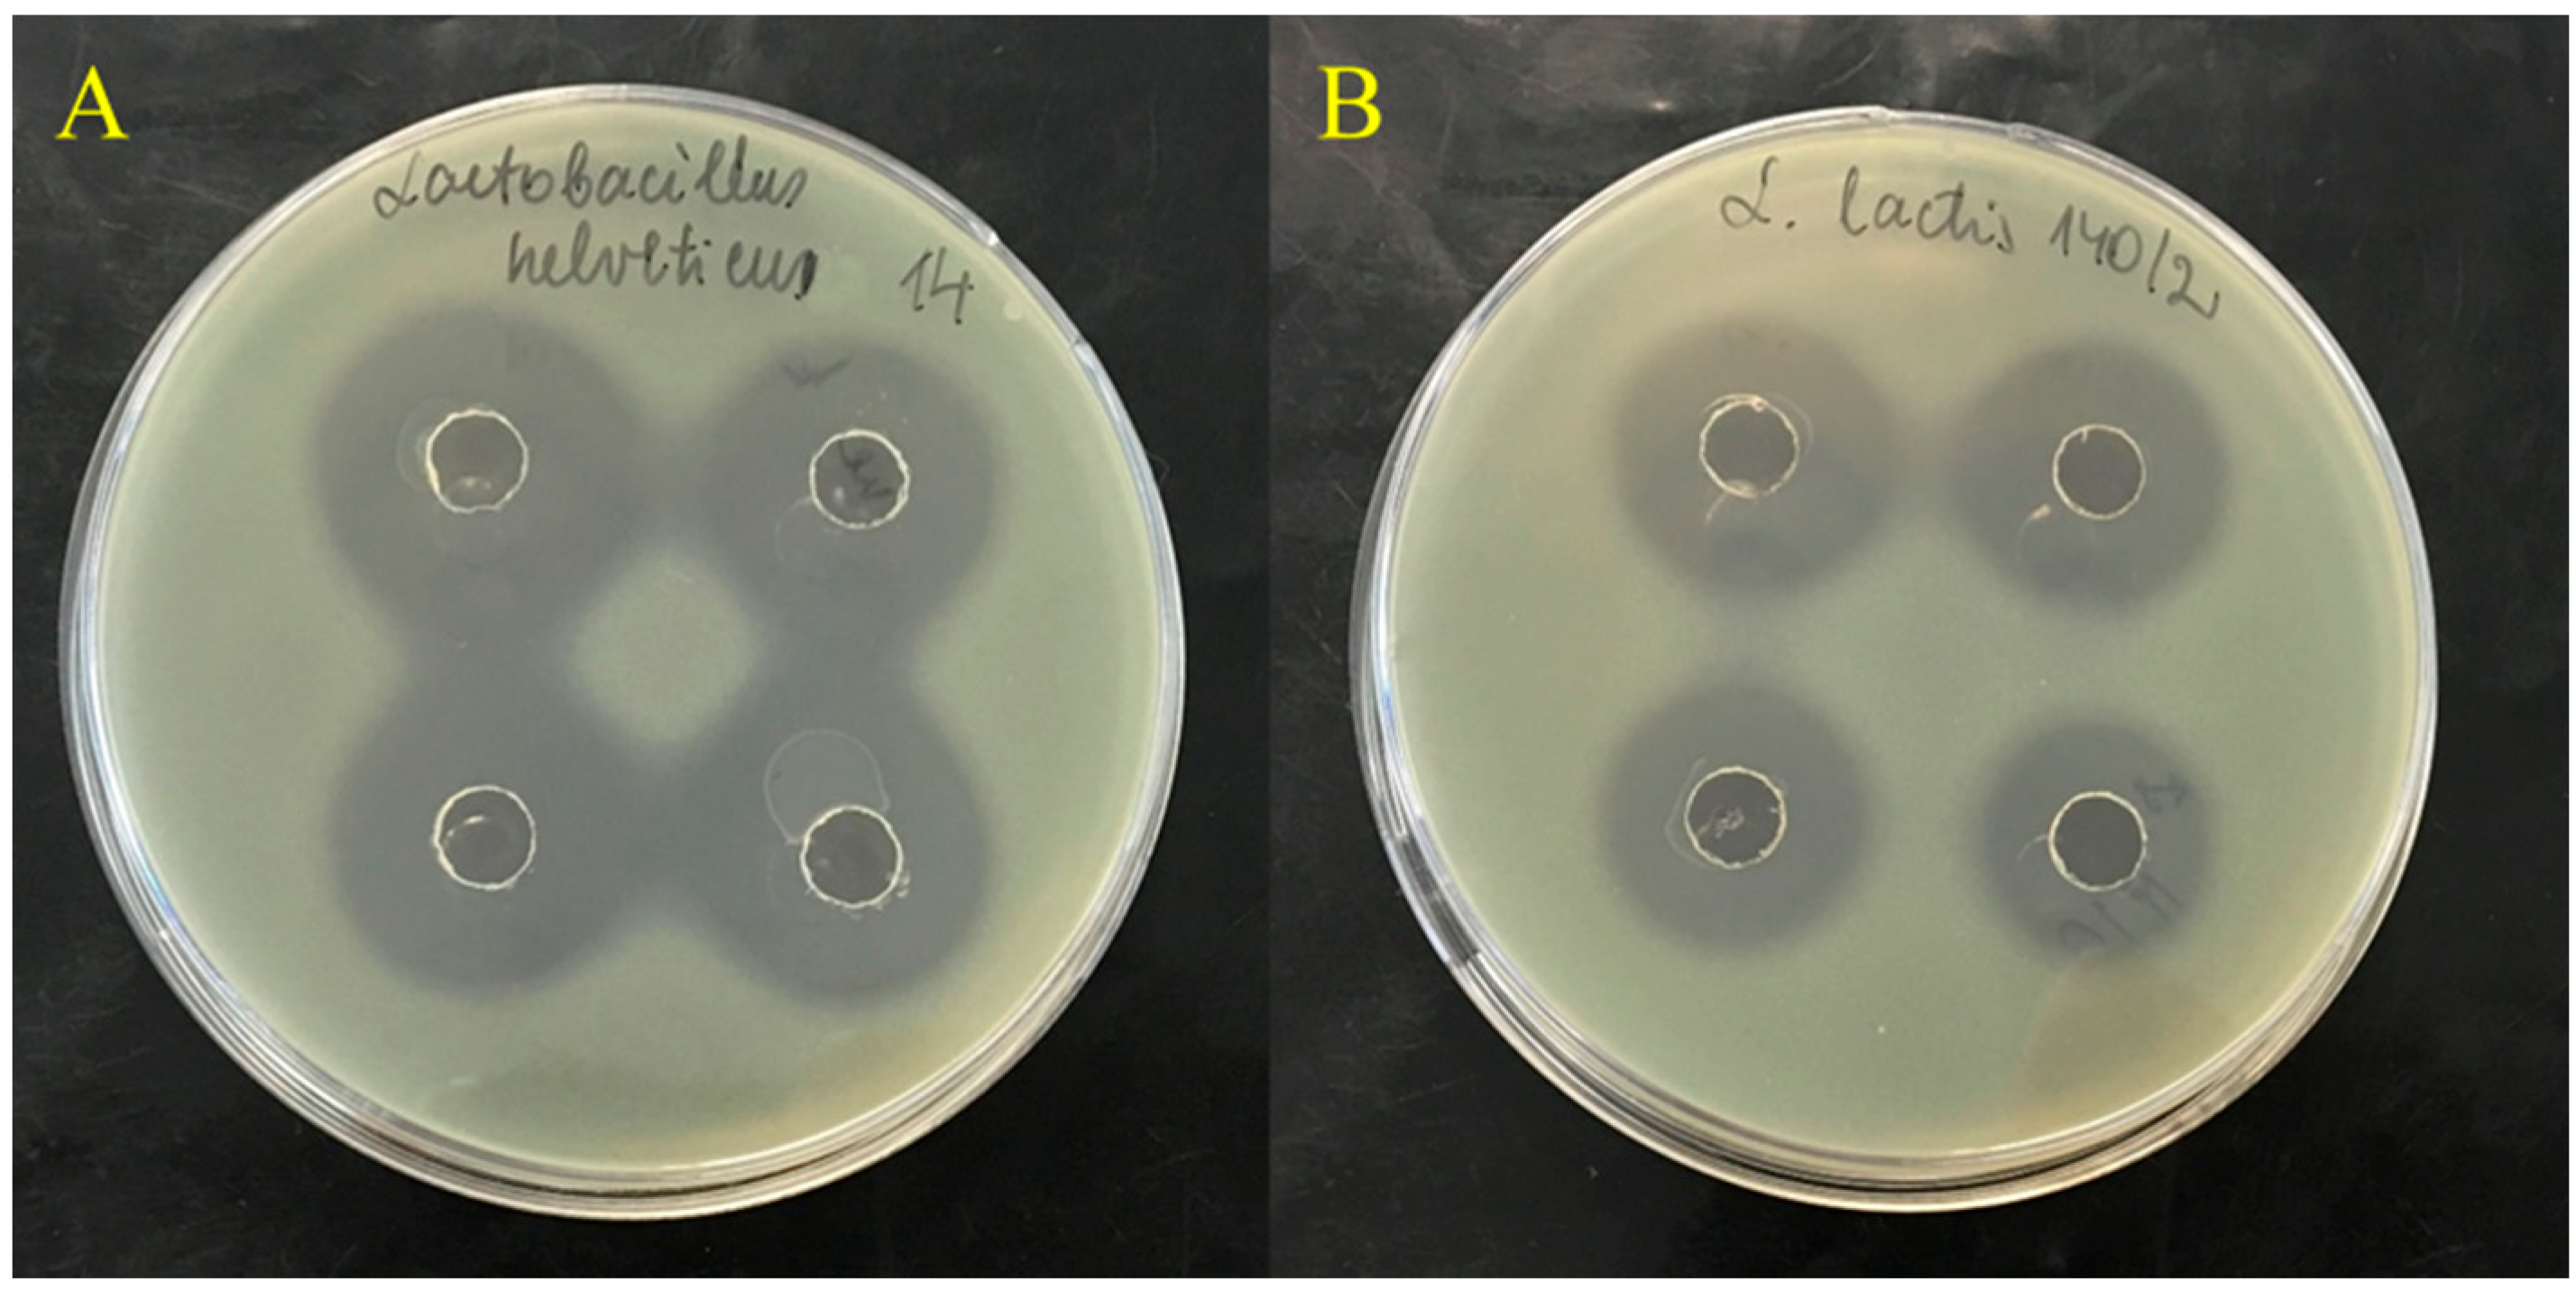
Horticulturae 08 00007 g002

Effects of Natural Antimicrobials on Xanthomonas Strains Growth
Abstract
:1. Introduction
2. Materials and Methods
2.1. Identification of Isolated Endophytic and Xanthomonas spp. Bacteria
2.2. Microorganisms and Growth Media
2.3. Determination of Antibacterial Activity
2.4. Cell-Free Supernatants of Lactic Acid Bacteria
2.5. Essential Oils
2.6. Blueberry and Cranberry Aqueous Extracts
2.7. Determination of Minimum Inhibitory Concentration (MIC)
2.8. Statistical Analysis
3. Results
3.1. Antibacterial Activity of Endophytic Bacterial Strains
3.2. Lactic Acid Bacteria Strains
3.3. Essential Oils and Aqueous Extracts of Berries
4. Discussion
5. Conclusions
Author Contributions
Funding
Institutional Review Board Statement
Informed Consent Statement
Data Availability Statement
Acknowledgments
Conflicts of Interest
References
- Savary, S.; Teng, P.S.; Willocquet, L.; Nutter, F.W., Jr. Quantification and modeling of crop losses: A review of purposes. Annu. Rev. Phytopathol. 2006, 44, 89–112. [Google Scholar] [CrossRef]
- Mansfield, J.; Genin, S.; Magori, S.; Citovsky, V.; Sriariyanum, M.; Ronald, P.; Dow, M.; Verdier, V.; Beer, S.V.; Machado, M.A.; et al. Top 10 plant pathogenic bacteria in molecular plant pathology. Mol. Plant Pathol. 2012, 13, 614–629. [Google Scholar] [CrossRef] [PubMed] [Green Version]
- Kannan, V.R.; Bastas, K.K. (Eds.) Sustainable Approaches to Controlling Plant Pathogenic Bacteria, 1st ed.; CRC Press: Boca Raton, FL, USA, 2015. [Google Scholar] [CrossRef]
- Burdon, J.J.; Zhan, J. Climate change and disease in plant communities. PLoS Biol. 2020, 18, e3000949. [Google Scholar] [CrossRef] [PubMed]
- Juroszek, P.; Racca, P.; Link, S.; Farhumand, J.; Kleinhenz, B. Overview on the review articles published during the past 30 years relating to the potential climate change effects on plant pathogens and crop disease risks. Plant Pathol. 2020, 69, 179–193. [Google Scholar] [CrossRef]
- Alengebawy, A.; Abdelkhalek, S.T.; Qureshi, S.R.; Wang, M.-Q. Heavy metals and pesticides toxicity in agricultural soil and plants: Ecological risks and human health implications. Toxics 2021, 9, 42. [Google Scholar] [CrossRef]
- Lamichhane, J.R.; Osdaghi, E.; Behlau, F. Thirteen decades of antimicrobial copper compounds applied in agriculture. A review. Agron. Sustain. Dev. 2018, 38, 28. [Google Scholar] [CrossRef] [Green Version]
- Majumdar, T.D.; Singh, M.; Thapa, M.; Dutta, M.; Mukherjee, A.; Kumar, G.C. Size-dependent antibacterial activity of copper nanoparticles against Xanthomonas oryzae pv. oryzae—A synthetic and mechanistic approach. Colloid Interface Sci. Commun. 2019, 32, 100190. [Google Scholar] [CrossRef]
- Behlau, F.; Gochez, A.M.; Jones, J.B. Diversity and copper resistance of Xanthomonas affecting citrus. Trop. Plant Pathol. 2020, 45, 200–212. [Google Scholar] [CrossRef]
- Alonso-Gato, M.; Astray, G.; Mejuto, J.C.; Simal-Gandara, J. Essential Oils as Antimicrobials in Crop Protection. Antibiotics 2021, 10, 34. [Google Scholar] [CrossRef]
- Marin, V.R.; Ferrarezi, J.H.; Vieira, G.; Sass, D.C. Recent advances in the biocontrol of Xanthomonas spp. World J. Microbiol. Biotechnol. 2019, 35, 72. [Google Scholar] [CrossRef]
- Quinto, E.J.; Caro, I.; Villalobos-Delgado, L.H.; Mateo, J.; De-Mateo-Silleras, B.; Redondo-Del-Río, M.P. Food safety through natural antimicrobials. Antibiotics 2019, 8, 208. [Google Scholar] [CrossRef] [PubMed] [Green Version]
- Raymaekers, K.; Ponet, L.; Holtappels, D.; Berckmans, B.; Cammue, B.P. Screening for novel biocontrol agents applicable in plant disease management–a review. Biol. Control. 2020, 144, 104240. [Google Scholar] [CrossRef]
- Stefani, E.; Obradović, A.; Gašić, K.; Altin, I.; Nagy, I.K.; Kovács, T. Bacteriophage-Mediated Control of Phytopathogenic Xanthomonads: A Promising Green Solution for the Future. Microorganisms 2021, 9, 1056. [Google Scholar] [CrossRef]
- Afzal, I.; Shinwari, Z.K.; Sikandar, S.; Shahzad, S. Plant beneficial endophytic bacteria: Mechanisms, diversity, host range and genetic determinants. Microbiol. Res. 2019, 221, 36–49. [Google Scholar] [CrossRef] [PubMed]
- Bajpai, V.K.; Kang, S.-R.; Xu, H.; Lee, S.-G.; Baek, K.-H.; Kang, S.-C. Potential Roles of Essential Oils on Controlling Plant Pathogenic Bacteria Xanthomonas Species: A Review. Plant Pathol. J. 2011, 27, 207–224. [Google Scholar] [CrossRef] [Green Version]
- Montesinos, E. Antimicrobial peptides and plant disease control. FEMS Microbiol. Lett. 2007, 270, 1–11. [Google Scholar] [CrossRef] [Green Version]
- Lelliott, R.A.; Stead, D.E. British Society for Plant Pathology. In Methods for the Diagnosis of Bacterial Diseases of Plants; Published on behalf of the British Society for Plant Pathology by Blackwell Scientific Publications; Oxford Press: Oxford, UK, 1987. [Google Scholar]
- Schaad, N.W.; Jones, J.B.; Chun, W. Laboratory Guide for the Identification of Plant Pathogenic Bacteria, 3rd ed.; American Phytopathological Society: Saint Paul, MN, USA, 2001. [Google Scholar]
- Klement, Z. Method for the rapid detection of the pathogenicity of phytopathogenic pseudomonads. Nature 1963, 199, 299–300. [Google Scholar] [CrossRef] [PubMed]
- Janse, J.D. Phytobacteriology: Principles and Practice; CABI: Wallingford, UK, 2005. [Google Scholar]
- Kałużna, M.; Janse, J.D.; Young, J.M. Detection and identification methods and new tests as used and developed in the framework of COST 873 for bacteria pathogenic to stone fruits and nuts Pseudomonas syringae pathovars. J. Plant Pathol. 2012, 94, 117–126. [Google Scholar] [CrossRef]
- Rosling, A.; Landeweert, R.; Lindahl, B.D.; Larsson, K.-H.; Kuyper, T.W.; Taylor, A.F.S.; Finlay, R.D. Vertical distribution of ectomycorrhizal fungal taxa in a podzol soil profile. New Phytologist. 2003, 159, 775–783. [Google Scholar] [CrossRef]
- Salah, M.A.; Martinez, I. Universal and rapid salt-extraction of high-quality genomic DNA for PCR-based techniques. Nucleic Acids Res. 1997, 25, 4692–4693. [Google Scholar] [CrossRef]
- Maes, M. Fast classification of plant-associated bacteria in the Xanthomonas genus. FEMS Microbiol. Lett. 1993, 113, 161–165. [Google Scholar] [CrossRef]
- Lane, D.J. 16S/23S rRNA Sequencing. In Nucleic Acid Techniques in Bacterial Systematic; Stackebrandt, E., Goodfellow, M., Eds.; John Wiley and Sons: New York, NY, USA, 1991; pp. 115–175. [Google Scholar]
- NCBI. Available online: https://www.ncbi.nlm.nih.gov (accessed on 3 November 2021).
- Šalomskienė, J.; Abraitienė, A.; Jonkuvienė, D.; Mačionienė, I.; Repečkienė, J. Selection of enhanced antimicrobial activity posing lactic acid bacteria characterised by (GTG)5-PCR fingerprinting. J. Food Sci. Technol. 2015, 52, 4124–4134. [Google Scholar] [CrossRef] [Green Version]
- Rahman, A.; Islam, R.; Al-Reza, S.M.; Kang, S.C. In vitro control of plant pathogenic Xanthomonas spp. using Poncirus trifoliata Rafin. EXCLI J. 2014, 13, 1104–1110. [Google Scholar] [CrossRef]
- Soleimani, N.; Kermanshahi, R.K.; Yakhchali, B.; Sattari, T.N. Antagonistic activity of probiotic lactobacilli against Staphylococcus aureus isolated from bovine mastitis. Afr. J. Microbiol. Res. 2010, 4, 2169–2173. [Google Scholar]
- Hammer, K.A.; Carson, C.F.; Riley, T.V. Antimicrobial activity of essential oils and other plant extracts. J. Appl. Microbiol. 1999, 86, 985–990. [Google Scholar] [CrossRef] [Green Version]
- Chudasama, K.S.; Thaker, V.S. Screening of potential antimicrobial compounds against Xanthomonas campestris from 100 essential oils of aromatic plants used in India: An ecofriendly approach. Arch. Phytopathol. Plant Prot. 2012, 45, 783–795. [Google Scholar] [CrossRef]
- Narayanasamy, P. Mechanisms of Action of Bacterial Biological Control Agents. In Biological Management of Diseases of Crops; Springer: Dordrecht, The Netherlands, 2013; pp. 295–429. [Google Scholar] [CrossRef]
- Dimkić, I.; Stanković, S.; Nišavić, M.; Petković, M.; Ristivojević, P.; Fira, D.; Berić, T. The Profile and Antimicrobial Activity of Bacillus Lipopeptide Extracts of Five Potential Biocontrol Strains. Front. Microbiol. 2017, 8, 925. [Google Scholar] [CrossRef] [Green Version]
- Medeot, D.B.; Fernandez, M.; Morales, G.M.; Jofré, E. Fengycins from Bacillus amyloliquefaciens MEP218 Exhibit Antibacterial Activity by Producing Alterations on the Cell Surface of the Pathogens Xanthomonas axonopodis pv. vesicatoria and Pseudomonas aeruginosa PA01. Front. Microbiol. 2020, 10, 3107. [Google Scholar] [CrossRef]
- Fu, B.; Zou, L.; Lee, C.; Wang, L. Antagonism and biocontrol of walnut blight by sweet osmanthus endophytic bacterium OFE17. J. Plant Pathol. 2021, 103, 1243–1252. [Google Scholar] [CrossRef]
- Minervini, F.; Celano, G.; Lattanzi, A.; Tedone, L.; De Mastro, G.; Gobbetti, M.; De Angelis, M. Lactic Acid Bacteria in Durum Wheat Flour Are Endophytic Components of the Plant during Its Entire Life Cycle. Appl. Environ. Microbiol. 2015, 81, 6736–6748. [Google Scholar] [CrossRef] [Green Version]
- Šalomskienė, J.; Abraitienė, A.; Jonkuvienė, D.; Mačionienė, I.; Repečkienė, J.; Stankienė, J.; Vaičiulytė-Funk, L. Changes in antagonistic activity of lactic acid bacteria induced by their response to technological factors. Agric. Food Sci. 2015, 24, 289–299. [Google Scholar] [CrossRef]
- Salomskiene, J.; Jonkuviene, D.; Macioniene, I.; Asta Abraitiene, A.; Zeime, J.; Repeckiene, J.; Vaiciulyte-Funk, L. Differences in the occurrence and efficiency of antimicrobial compounds produced by lactic acid bacteria. Eur. Food Res. Technol. 2019, 245, 569–579. [Google Scholar] [CrossRef]
- Fira, D.; Dimkić, I.; Berić, T.; Lozo, J.; Stanković, S. Biological control of plant pathogens by Bacillus species. J. Biotechnol. 2018, 285, 44–55. [Google Scholar] [CrossRef]
- Daranas, N.; Roselló, G.; Cabrefiga, J.; Donati, I.; Francés, J.; Badosa, E.; Spinelli, F.; Montesinos, E.; Bonaterra, A. Biological control of bacterial plant diseases with Lactobacillus plantarum strains selected for their broad-spectrum activity. Ann. Appl. Biol. 2019, 174, 92–105. [Google Scholar] [CrossRef] [PubMed] [Green Version]
- Shrestha, A.; Kim, B.S.; Park, D.H. Biological control of bacterial spot disease and plant growth-promoting effects of lactic acid bacteria on pepper. Biocontrol Sci. Technol. 2014, 24, 763–779. [Google Scholar] [CrossRef]
- Blainski, J.M.L.; da Rocha Neto, A.C.; Schimidt, E.C.; Voltolini, J.A.; Rossi, M.J.; Di Piero, R.M. Exopolysaccharides from Lactobacillus plantarum induce biochemical and physiological alterations in tomato plant against bacterial spot. Appl. Microbiol. Biotechnol. 2018, 102, 4741–4753. [Google Scholar] [CrossRef] [PubMed]
- Pandey, A.K.; Kumar, P.; Singh, P.; Tripathi, N.N.; Bajpai, V.K. Essential oils: Sources of antimicrobials and food preservatives. Front. Microbiol. 2017, 7, 2161. [Google Scholar] [CrossRef] [Green Version]
- Lo Cantore, P.; Shanmugaiah, V.; Iacobellis, N.S. Antibacterial activity of essential oil components and their potential use in seed disinfection. J. Agric. Food Chem. 2009, 57, 9454–9461. [Google Scholar] [CrossRef]
- Spizzirri, U.G.; Aiello, F.; Carullo, G.; Facente, A.; Restuccia, D. Nanotechnologies: An Innovative Tool to Release Natural Extracts with Antimicrobial Properties. Pharmaceutics 2021, 13, 230. [Google Scholar] [CrossRef]
- Vasinauskienė, M.; Radušienė, J.; Zitikaitė, I.; Survilienė, E. Antibacterial activities of essential oils from aromatic and medicinal plants against growth of phytopathogenic bacteria. Agron. Res. 2006, 4, 437–440. [Google Scholar]
- Horváth, G.; Szabó, L.; Lemberkovics, É.; Botz, L.; Kocsis, B. Characterization and TLC-bioautographic detection of essential oils from some Thymus taxa. Determination of the activity of the oils and their components against plant pathogenic bacteria. JPC-J. Planar Chromatogr.-Mod. TLC 2004, 17, 300–304. [Google Scholar] [CrossRef]
- Popović, T.; Milićević, Z.O.; Violeta, K.; Igor, R.; Vesela, J.; Aleksandra, K.S. A preliminary study of antibacterial activity of thirty essential oils against several important plant pathogenic bacteria. Pestic. Fitomed. 2019, 33, 185–195. [Google Scholar] [CrossRef] [Green Version]

| Antagonistic Bacteria Strain | Average Zone of Inhibition (ZOI), mm | ||||
|---|---|---|---|---|---|
| Xanthomonas spp. Strain | |||||
| X. translucens NRCIB X6 | X. arboricola NRCIB X7 | X. arboricola NRCIB X8 | X. arboricola NRCIB X9 | X. arboricola NRCIB X10 | |
| Pseudomonas sp. NRCIB P2 | 33.0 ± 0.0 d | 33.0 ± 0.0 d | 25.9 ± 0.5 b,f | 24.1 ± 0.4 a,f,g | 23.0 ± 0.5 b,d,g |
| Pseudomonas sp. NRCIB P1 | 32.7 ± 0.8 d | 31.2 ± 0.7 c | 23.2 ± 0.3 a,e,i | 24.0 ± 1.5 a,e,g | 23.7 ± 0.3 b,d,f,g |
| Pseudomonas sp. NRCIB P3 | 27.2 ± 0.4 e | 25.5 ± 0.6 b | 25.1 ± 0.8 a,b,g | 22.5 ± 0.6 d,g | 24.8 ± 1.4 c,g |
| Bacillus sp. NRCIB B5 | 24.6 ± 0.0 c | 25.2 ± 0.3 b | 22.7 ± 0.3 c,d,e,g | 22.9 ± 0.1 c,d,e,f | 22.2 ± 0.2 d,i |
| Bacillus sp. NRCIB B4 | 21.8 ± 0.5 a,g | 21.5 ± 0.6 a | 25.1 ± 0.7 a,b | 26.2 ± 1.1 a | 24.5 ± 1.4 b,c |
| Bacillus sp. NRCIB B1 | 22.2 ± 0.1 a | 21.0 ± 0.1 a | 23.5 ± 0.2 a,c,f | 25.1 ± 0.6 a,c | 25.2 ± 0.2 a,c,f |
| Bacillus sp. NRCIB B2 | - | 21.4 ± 0.2 a | 25.3 ± 0.2 a,b | 30.3 ± 0.5 b | 27.0 ± 0.4 a |
| Bacillus sp. NRCIB B3 | 21.2 ± 0.9 a,g | 20.6 ± 0.4 a | 26.8 ± 2.2 b | 25.4 ± 1.3 a | 23.0 ± 0.0 b,d,g |
| Bacillus sp. NRCIB B6 | 22.8 ± 0.8 a | 20.6 ± 0.2 a | 20.6 ± 0.1 d | 21.6 ± 0.3 d | 22.4 ± 0.2 d,e,i |
| Paenibacillus sp. NRCIB PB1 | 30.3 ± 0.2 f | 20.7 ± 0.3 a | 16.5 ± 0.2 h | 17.0 ± 0.1 h | 16.4 ± 0.6 h |
| K * | 20.3 ± 1.2 g | 21.8 ± 0.8 a | 21.0 ± 0.9 d,i | 20.8 ± 0.6 d,i | 20.5 ± 0.6 i |
| Lactic acid Bacteria Strain | Average Zone of Inhibition (ZOI), mm | ||||
|---|---|---|---|---|---|
| Xanthomonas spp. Strain | |||||
| X. translucens NRCIB X6 | X. arboricola NRCIB X7 | X. arboricola NRCIB X8 | X. arboricola NRCIB X9 | X. arboricola NRCIB X10 | |
| L. lactis 140/2 | 20.1 ± 0.6 a | 20.9 ± 1.0 a | 20.6 ± 0.8 a | 22.0 ± 1.0 b,e | 22.5 ± 1.0 a |
| L. lactis 57 | 19.1 ± 0.9 a | 20.0 ± 0.2 a,b | 19.8 ± 1.0 a | 20.0 ± 1.0 a,b | 22.0 ± 1.0 a |
| L. lactis 768/5 | 18.5 ± 0.6 a | 18.3 ± 0.5 b | 19.3 ± 0.7 a | 18.5 ± 0.6 a | 20.8 ± 1.0 a |
| E. faecium 59/30 | 17.9 ± 0.3 a | 19.8 ± 0.5 a,b | 19.0 ± 0.8 a | 19.0 ± 0.8 a | 20.5 ± 0.6 a |
| E. faecium 41/2 | 19.3 ± 0.5 a | 20.3 ± 1.0 a,b | 19.8 ± 0.5 a | 19.5 ± 0.6 a | 20.8 ± 0.8 a |
| Lb. helveticus 14 | 23.3 ± 1.0 c | 29.0 ± 0.8 c,g | 25.3 ± 1.0 c | 28.8 ± 1.2 c | 26.5 ± 1.0 c |
| Lb. helveticus 3 | 29.5 ± 1.0 b,d | 28.5 ± 1.0 d,e | 28.3 ± 1.0 c,d | 28.5 ± 1.0 c,d | 30.0 ± 0.8 b,d,e |
| Lb. helveticus 148/3 | 32.0 ± 0.8 b | 29.3 ± 1.0 c,g | 32.0 ± 0.2 b | 28.8 ± 1.0 c,d | 30.0 ± 0.8 b,d,e |
| Lb. helveticus R | 27.3 ± 1.0 d,f | 27.0 ± 1.0 c,d | 27.3 ± 1.0 c,d | 27.0 ± 1.0 d | 31.0 ± 1.0 b |
| S. thermophilus 43 | 19.8 ± 0.5 a | 18.8 ± 0.5 b,f | 20.0 ± 0.8 a | 18.9 ± 1.0 a | 21.5 ± 1.0 a |
| Lb. reuteri 3 | 27.1 ± 1.0 d,e,f | 24.5 ± 0.6 e | 27.3 ± 1.2 c,d | 24.8 ± 1.0 e | 26.0 ± 1.0 c,d |
| Lb. reuteri 7 | 26.0 ± 1.0 f | 25.3 ± 1.0 d,e | 27.0 ± 1.0 c,d | 28.0 ± 1.2 c,d | 26.8 ± 1.0 c,e |
| K * | 28.3 ± 1.0 d,f,g | 29.8 ± 0.5 g | 29.0 ± 1.0 b,d | 28.8 ± 1.0 c,d | 28.5 ± 1.0 b,c |
| Essential Oil | Concentration, % | Average Zone of Inhibition, mm | ||||
|---|---|---|---|---|---|---|
| Xanthomonas spp. Strain | ||||||
| X. translucens NRCIB X6 | X. arboricola NRCIB X7 | X. arboricola NRCIB X8 | X. arboricola NRCIB X9 | X. arboricola NRCIB X10 | ||
| Rosemary (Rosmarinus officinalis) | 1 | 0.0 ± 0.0 b | 0.0 ± 0.0 c | 9.0 ± 0.1 i | 0.0 ± 0.0 b | 0.0 ± 0.0 c |
| 2 | 0.0 ± 0.0 b | 0.0 ± 0.0 c | 10.0 ± 0.1 e | 11.0 ± 0.0 g,h,i | 9.0 ± 0.0 h | |
| Lemon (Citrus limon) | 1 | 0.0 ± 0.0 b | 0.0 ± 0.0 c | 0.0 ± 0.0 b | 0.0 ± 0.0 b | 0.0 ± 0.0 c |
| 2 | 0.0 ± 0.0 b | 0.0 ± 0.0 c | 0.0 ± 0.0 b | 0.0 ± 0.0 b | 0.0 ± 0.0 c | |
| Thyme (Thymus vulgaris) | 1 | 16.0 ± 0.0 c | 11.0 ± 0.0 a | 16.5 ± 0.1c | 14.0 ± 0.0 c | 17.0 ± 0.1 d |
| 2 | 22.0 ± 0.1 d | 18.0 ± 0.1 d | 20.0 ± 0.1 d | 28.0 ± 0.2 d | 26.0 ± 0.2 e | |
| Grapefruit (Citrus paradisi) | 1 | 11.0 ± 0.1 e | 10.0 ± 0.1 e | 10.0 ± 0.1 e | 10.5 ± 0.2 e,h | 10.0 ± 0.0 a |
| 2 | 14.5 ± 0.5 f | 11.0 ± 0.1 a | 11.0 ± 0.1 f | 12.3 ± 0.2 a | 12.0 ± 0.1 f | |
| Peppermint (Mentha piperita) | 1 | 0.0 ± 0.0 b | 0.0 ± 0.0 c | 0.0 ± 0.0 b | 0.0 ± 0.0 b | 0.0 ± 0.0 c |
| 2 | 11.0 ± 0.1 e,g | 10.0 ± 0.0 e | 11.0 ± 0.0 f,h | 10.0 ± 0.0 e | 11.0 ± 0.0 b | |
| Pine (Pinus sylvestris) | 1 | 0.0 ± 0.0 b | 0.0 ± 0.0 c | 0.0 ± 0.0 b | 0.0 ± 0.0 b | 0.0 ± 0.0 c |
| 2 | 0.0 ± 0.0 b | 0.0 ± 0.0 c | 0.0 ± 0.0 b | 0.0 ± 0.0 b | 0.0 ± 0.0 c | |
| Lavender (Lavandula angustifolia) | 1 | 11.5 ± 0.1 a,e | 11.5 ± 0.0 f | 11.5 ± 0.0 a,f | 11.5 ± 0.1 a,i | 10.5 ± 0.0 a,b |
| 2 | 15.0 ± 0.0 f | 15.0 ± 0.1 g | 14.5 ± 0.0 g | 15.5 ± 0.1 f | 13.5 ± 0.0 g | |
| Tea tree (Melaleuca alterfolia) | 1 | 11.5 ± 0.0 a,e | 11.2 ± 0.1 a,f | 11.3 ± 0.2 a,f | 11.5 ± 0.0 a,g | 10.0 ± 0.1 a |
| 2 | 12.0 ± 0.1 a | 12.0 ± 0.1 b | 12.0 ± 0.1 a | 12.0 ± 0.1 a | 11.0 ± 0.2 b | |
| Silver fir (Abies sibirica) | 1 | 0.0 ± 0.0 b | 0.0 ± 0.0 c | 0.0 ± 0.0 b | 0.0 ± 0.0 b | 0.0 ± 0.0 c |
| 2 | 0.0 ± 0.0 b | 0.0 ± 0.0 c | 0.0 ± 0.0 b | 0.0 ± 0.0 b | 0.0 ± 0.0 c | |
| Juniper (Juniperus communis) | 1 | 0.0 ± 0.0 b | 0.0 ± 0.0 c | 0.0 ± 0.0 b | 0.0 ± 0.0 b | 0.0 ± 0.0 c |
| 2 | 0.0 ± 0.0 b | 0.0 ± 0.0 c | 0.0 ± 0.0 b | 0.0 ± 0.0 b | 0.0 ± 0.0 c | |
| Berry Extract (Country) | Berry Location Sites Number | Average Zone of Inhibition, mm | ||||
|---|---|---|---|---|---|---|
| Xanthomonas spp. Strains | ||||||
| X. translucens NRCIB X6 | X. arboricola NRCIB X7 | X. arboricola NRCIB X8 | X. arboricola NRCIB X9 | X. arboricola NRCIB X10 | ||
| Blueberry (Lithuania) | 1 | 11.0 ± 0.0 a | 11.0 ± 0.0 a | 11.0 ± 0.0 a | 11.5 ± 0.0 a,c,e,f,g,h,j,k | 12.0 ± 0.0 a |
| 2 | 11.0 ± 0.0 a | 11.0 ± 0.0 a | 11.0 ± 0.0 a | 11.0 ± 0.0 a,b | 12.0 ± 0.0 a | |
| 3 | 11.0 ± 0.0 a | 10.0 ± 0.0 b | 10.0 ± 0.1 b | 12.0 ± 0.0 c | 13.0 ± 0.0 b | |
| Blueberry (Finland) | 1 | 10.0 ± 0.0 b | 10.0 ± 0.0 b | 10.0 ± 0.0 b | 11.0 ± 0.0 b,j | 11.0 ± 0.0 c |
| 2 | 10.0 ± 0.0 b | 10.0 ± 0.0 b | 10.0 ± 0.0 b | 11.0 ± 0.0 b,k | 11.0 ± 0.0 c | |
| 3 | 10.0 ± 0.0 b | 10.0 ± 0.0 b | 10.0 ± 0.0 b | 12.0 ± 0.0 c,l | 12.0 ± 0.0 a | |
| Blueberry (Latvia) | 1 | 11.0 ± 0.0 a | 11.0 ± 0.0 a | 11.0 ± 0.0 a | 12.0 ± 0.0 c,d | 12.0 ± 0.0 a |
| 2 | 11.0 ± 0.0 a | 11.0 ± 0.0 a | 11.0 ± 0.0 a | 11.0 ± 0.0 b,e | 11.0 ± 0.0 c | |
| 3 | 11.0 ± 0.1 a | 11.0 ± 0.0 a | 11.0 ± 0.0 a | 11.2 ± 0.0 b,f | 11.0 ± 0.0 c | |
| Blueberry (Norway) | 1 | 10.0 ± 0.0 b | 10.0 ± 0.0 b | 10.0 ± 0.0 b | 11.0 ± 0.0 b,g | 11.0 ± 0.0 c |
| 2 | 10.0 ± 0.0 b | 10.0 ± 0.0 b | 10.0 ± 0.0 b | 11.0 ± 0.0 b,h | 11.0 ± 0.0 c | |
| 3 | 11.0 ± 0.0 a | 11.0 ± 0.0 a | 11.0 ± 0.0 a | 12.0 ± 0.0 c,i | 12.0 ± 0.0 a | |
| Cranberry (Lithuania) | 1 | 17.8 ± 0.3 c | 18.1 ± 0.2 c | 17.8 ± 0.4 c | 18.1 ± 0.2 m | 17.5 ± 0.5 d |
| 2 | 17.5 ± 0.1 c | 17.8 ± 0.3 c | 17.1 ± 0.2 c | 17.8 ± 0.5 m | 16.8 ± 0.1 e | |
Publisher’s Note: MDPI stays neutral with regard to jurisdictional claims in published maps and institutional affiliations. |
© 2021 by the authors. Licensee MDPI, Basel, Switzerland. This article is an open access article distributed under the terms and conditions of the Creative Commons Attribution (CC BY) license (https://creativecommons.org/licenses/by/4.0/).
Share and Cite
Mačionienė, I.; Čepukoit, D.; Šalomskienė, J.; Černauskas, D.; Burokienė, D.; Šalaševičienė, A. Effects of Natural Antimicrobials on Xanthomonas Strains Growth. Horticulturae 2022, 8, 7. https://doi.org/10.3390/horticulturae8010007
Mačionienė I, Čepukoit D, Šalomskienė J, Černauskas D, Burokienė D, Šalaševičienė A. Effects of Natural Antimicrobials on Xanthomonas Strains Growth. Horticulturae. 2022; 8(1):7. https://doi.org/10.3390/horticulturae8010007
Chicago/Turabian StyleMačionienė, Irena, Dovilė Čepukoit, Joana Šalomskienė, Darius Černauskas, Daiva Burokienė, and Alvija Šalaševičienė. 2022. "Effects of Natural Antimicrobials on Xanthomonas Strains Growth" Horticulturae 8, no. 1: 7. https://doi.org/10.3390/horticulturae8010007
APA StyleMačionienė, I., Čepukoit, D., Šalomskienė, J., Černauskas, D., Burokienė, D., & Šalaševičienė, A. (2022). Effects of Natural Antimicrobials on Xanthomonas Strains Growth. Horticulturae, 8(1), 7. https://doi.org/10.3390/horticulturae8010007

